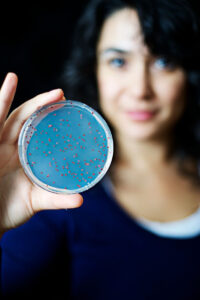

NASA’da görevli astrobiyolog Prof. Dr. Betül Kaçar başarısıyla Türkiye’nin gururu oldu. 4 milyar yıl öncesine ait bir bakteriyi antik DNA ile klonlayarak tekrar canlandıran Kaçar, geçmiş yaşamın anlaşılmasını sağlayacak yeni bir çalışmaya başladıklarını açıkladı.